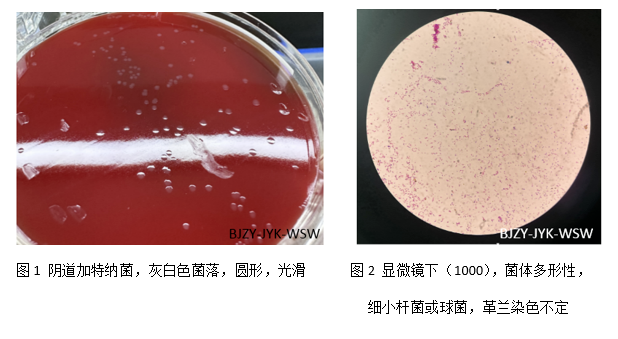

近日,首都医科大学附属北京中医医院医学检验科微生物室采用基质辅助激光解吸/电离飞行时间质谱(MALDI-TOF MS)鉴定技术从一例乳腺癌术后患者的清洁中段尿样本中分离出阴道加特纳菌(gardnrella vaginallis,GV)。
阴道加特纳菌是与性接触传播有关的病原体,该菌的分离可支持细菌性阴道病(bacterial vaginosis,BV)的诊断,还可引起输卵管炎、流产、早产和尿路感染等病症。
GV与细菌性阴道炎的发生高度相关,流产史、年龄大于40岁为细菌性阴道炎感染的独立高危因素。GV生长缓慢、营养要求较高,这让临床分离率较低,容易造成漏检。
GV主要寄生在女性阴道内,当女性患者免疫力下降而GV又大量繁殖时,GV容易移行进人尿道而引起尿路感染。男性患者可能是在尿道发生炎症损伤、局部免疫力下降或使用大剂量抗生素使尿道菌群失调情况下通过性接触而感染GV。
我院检验科微生物专业组于2008年通过ISO15189医学实验室质量和能力认可,将传统的手工技术与先进的自动化仪器设备相结合,为感染性疾病的诊断与治疗提供准确可靠的实验室依据,为医院感染的控制提供病原学依据,是医院控制医院感染的重要技术力量。
现已开展各类样本的细菌真菌培养、鉴定、药敏定量试验、真菌血清学检测等40余项,具有革兰染色、抗酸染色、墨汁染色、真菌荧光染色等各种染色技术。配有梅里埃VITEK2 COMPACT全自动微生物鉴定及药敏分析系统、梅里埃Bact/ALERT VITRTUO 全自动微生物培养系统、自动化细菌分离培养仪等仪器设备,质谱仪的投入使用,大幅度提升了我科鉴定细菌、真菌的能力,标志着我院医学检验科的微生物鉴定水平迈上新台阶。
健康贴士:阴道加特纳菌如何预防?
1.养成健康的生活习惯,宜清淡饮食,忌辛辣刺激性食物,锻炼身体,提高机体免疫力。
2.积极治疗糖尿病等基础疾病。
3.注意个人卫生,勤换内衣裤,保持外阴清洁干燥。
4.加强自我保护意识,防止交叉感染。